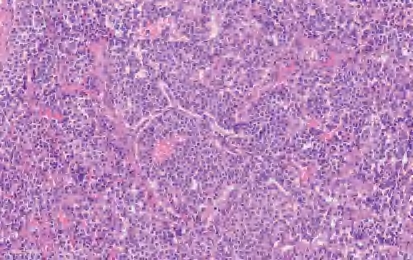

肺神经内分泌肿瘤(lung neuroendocrine neoplasm,LNEN)分为神经内分泌肿瘤(neuroendocrine tumours,NET)和神经内分泌癌(neuroendocrine carcinoma,NEC)两大类。其中:NET包括低级别的典型类癌(typical carcinoid,TC)和中级别的不典型类癌(atypical carcinoid,AC);NEC包括大细胞神经内分泌癌(large cell neuroendocrine carcinoma,LCNEC)和小细胞肺癌(small cell lung carcinoma,SCLC)。肺神经内分泌肿瘤常具有神经内分泌形态,如器官样生长模式伴梁状、菊形团、岛状、栅栏状、条带状、假腺体样或实体型,而真正的腺腔或乳头是不常见的。
弥漫性特发性肺神经内分泌细胞增生(diffuse idiopathic pulmonary neuroendocrine cell hyperplasia,DIPNECH)是与NEN的多灶性增生。它是一种浸润前病变,可能发展为类癌。DIPNECH可能伴有收缩性细支气管纤维化。
【ICD-O编码】8040/0。
【ICD-11编码】2F00.Y。
【镜下形态】神经内分泌细胞增生是由支气管黏膜内神经内分泌细胞聚集或增生形成的。神经内分泌细胞的核呈圆形、椭圆形或梭形,染色质为胡椒盐样,胞质中等呈双嗜性或嗜酸性。神经内分泌细胞结节性增生浸润细支气管壁<0.5 cm的被归类为微瘤型类癌。DIPNECH表达神经内分泌标志物如Syn、CgA、CD56、广谱CK及TTF-1(通常表达强度不及肺泡上皮),不表达p40/p63和高分子量CK。DIPNECH应注意与继发于气道炎症、肉芽肿、纤维化或高海拔的神经内分泌细胞增生鉴别。在75%的类癌中,非肿瘤区域肺实质可偶见肿瘤和(或)神经内分泌细胞增生。
直径≥0.5 cm的神经内分泌细胞的结节性增生被诊断为类癌。应将DIPNECH与神经内分泌细胞增生区分开来,后者发生在婴幼儿中。DIPNECH的病理诊断需基于外科肺切除标本,小活检标本检查不能作出明确的病理诊断。
【诊断分子病理学】尚无与其相关的分子检测方法。
【定义】类癌是恶性LNEN伴分化良好的器官样结构,它包括两类:典型类癌(TC),核分裂<2个/2 mm 2 ,缺乏坏死(图2-13);不典型类癌(AC),核分裂为2~10个/2 mm 2 和(或)坏死,通常为点灶状(图2-14)。
图2-13 TC

图2-14 AC
【ICD-O编码】
① 8240/3:类癌,非特指性/NET。
② 8240/3:TC/NET,1级。
③ 8249/3:AC/NET,2级。
【ICD-11编码】
① 2C25.4&XH9LV8:NET1级。
② 2C25.4&XH51K1:NET2级。
【镜下形态】TC和AC为分化好的NET伴有独特的肿瘤结构和细胞学特征。肿瘤细胞为小至中等大小,呈立方形、多角形或梭形(梭形细胞尤其易发生在周围型病变中),形态较一致,核仁不明显,核染色质呈细颗粒状、中至大量嗜酸性颗粒胞质。临床上TC为低级别,AC为中级别,二者的区别在于核分裂象和有无坏死。也可见到嗜酸性颗粒细胞、透明细胞和含色素的类癌。与LCNEC和SCLC不同,伴有SCC或腺癌的复合型类癌不常见。此外,类癌不与SCLC和LCNEC混合存在。罕见的类癌,形态符合不典型类癌,但核分裂象>10个/2 mm 2 或Ki-67增殖指数偏高(>30%),有限的病例基因学分析显示其与类癌关系密切,而不是SCLC和LCNEC(缺乏RB1或TP53基因突变,低的总肿瘤负荷或MEN1基因突变的存在)。类癌肿瘤细胞呈低分子CK阳性,高分子CK阴性;神经内分泌标记CgA、Syn、CD56、INSM1呈强阳性。周围型肿瘤TTF-1呈阳性,中央型肿瘤TTF-1呈阴性。尽管Ki-67增殖指数>5%更可能是AC,但Ki-67的增殖指数不是肺类癌的诊断标准,尤其在TC与AC的鉴别中。Ki-67的主要作用是在挤压的细胞学或小活检中排除SCLC或LCNEC。
【诊断分子病理学】目前尚无公认的肺类癌分子检测方法。
SCLC是一种恶性上皮性肿瘤,肿瘤细胞小、复合型SCLC具有非小细胞癌的其他组成部分,其中可能包括LCNEC、腺癌、SCC或LCC。复合性SCLC是指由SCLC和非小细胞癌(包括LCNEC)的其他成分组成的肿瘤。最常见的第二个成分是LCC、腺癌或SCC,但很少由梭形细胞癌或巨细胞癌组成。
【ICD-O编码】
① 8041/3:SCLC。
② 8045/3:复合性SCLC。
【ICD-11编码】2C25.1。
【镜下形态】SCLC肿瘤细胞胞质少,细胞边界不清,细胞核呈卵圆形和梭形,染色质呈细颗粒状,核仁不存在或不明显,核铸型常见。肿瘤细胞通常<3个静息小淋巴细胞的直径,密集排列并且以片状模式生长。细胞坏死和凋亡常见,并且广泛存在。可见挤压和血管周围嗜碱性核DNA壳形成(Azzopardi效应)的情况(图2-15)。通常不存在神经内分泌生长模式(器官样结构、梁状、菊形团等),但有时也可以出现,尤其是在切除的肿瘤中。偶见大细胞和巨细胞,但不应占肿瘤的10%以上(如超过10%,应诊断为复合性SCLC)。SCLC核分裂象多见,根据定义,核分裂象>10个/2 mm 2 ,但平均值为60个/2 mm 2 ,中位数为80个/2 mm 2 。SCLC通常表达CK(AE1/AE3)和CAM5.2,多为核旁点灶状,但不表达高分子量CK。大多数SCLC表达神经内分泌标志物,如CgA、Syn和CD56。5%~10%的SCLC这三种标志物可均呈阴性。研究表明,胰岛素瘤相关蛋白1(INSM1)是SCLC可靠的标志物。90%~95%的SCLC表达TTF-1(但肿瘤是否为肺起源没有特异性)。SCLC不表达NapsinA、p63和p40。
【诊断分子病理学】分子检测在SCLC诊断中的作用尚未确定。全基因组测序显示SCLC有 TP53 和 RB1 基因的双等位基因改变。

图2-15 SCLC
LCNEC是具有神经内分泌形态的高级别非小细胞癌,其核分裂象>10个/2 mm 2 ,表达一种或多种神经内分泌免疫组织化学标记。复合性LCNEC是具有腺癌、SCC、梭形细胞癌或巨细胞癌成分的LCNEC。
【ICD-O编码】8013/3。
【ICD-11编码】2C25.4&XHONL5。
【镜下形态】LCNEC具有神经内分泌形态学特征,如器官样生长模式伴梁状、菊形团、岛状、栅栏状、条带状、假腺体样或实体型。LCNEC的细胞学特征是中度到突出的核仁和中度至丰富的细胞质,染色质通常呈粗颗粒状或点状,但也可能呈泡状或具有中间状态,具有明显的细胞边界,细胞间膜可见。LCNEC的细胞大小通常>3个静息小淋巴细胞。一些LCNEC具有类似于SCLC(无明显核仁的颗粒状染色质)的细胞核特征,但由于细胞质丰富,仍可诊断为LCNEC。坏死几乎存在于所有LCNEC中,并且可形成较大的汇合区域,常可见间质内炎症细胞浸润。根据定义,LCNEC中的核分裂象超过10个/2 mm 2 ,但通常远远高于该值(中位数为70个/2 mm 2 )。复合性LCNEC最常见于腺癌,但也可能存在任何非神经内分泌非小细胞肺癌组织学类型。诊断LCNEC需要神经内分泌标志物的表达。在三种标准的神经内分泌标志物(Syn、CgA和CD56)中,大多数肿瘤表达两种及以上,应至少有一种神经内分泌标志物的表达,而且是弥漫性的。如果组织形态特征令人信服,任何程度的单个神经内分泌标志物都可用来支持LCNEC的诊断。由于NSE的特异性低,不建议使用。大约50%的LCNEC表达TTF-1。NapsinA可呈完全阴性或在少数LCNEC中呈弱/灶性表达。LCNEC可见散在的鳞状细胞标志物(p40/p63、CK5/6和34βE12)的表达,但不呈弥漫阳性。广谱CK通常在LCNEC中呈弥漫强阳性,LCNEC中Ki-67增殖指数常>30%。
【诊断分子病理学】NSCLC的致癌驱动因子(如EGFR和ALK)在LCNEC中的发生率较低,并且这些患者可能对靶向治疗有反应。